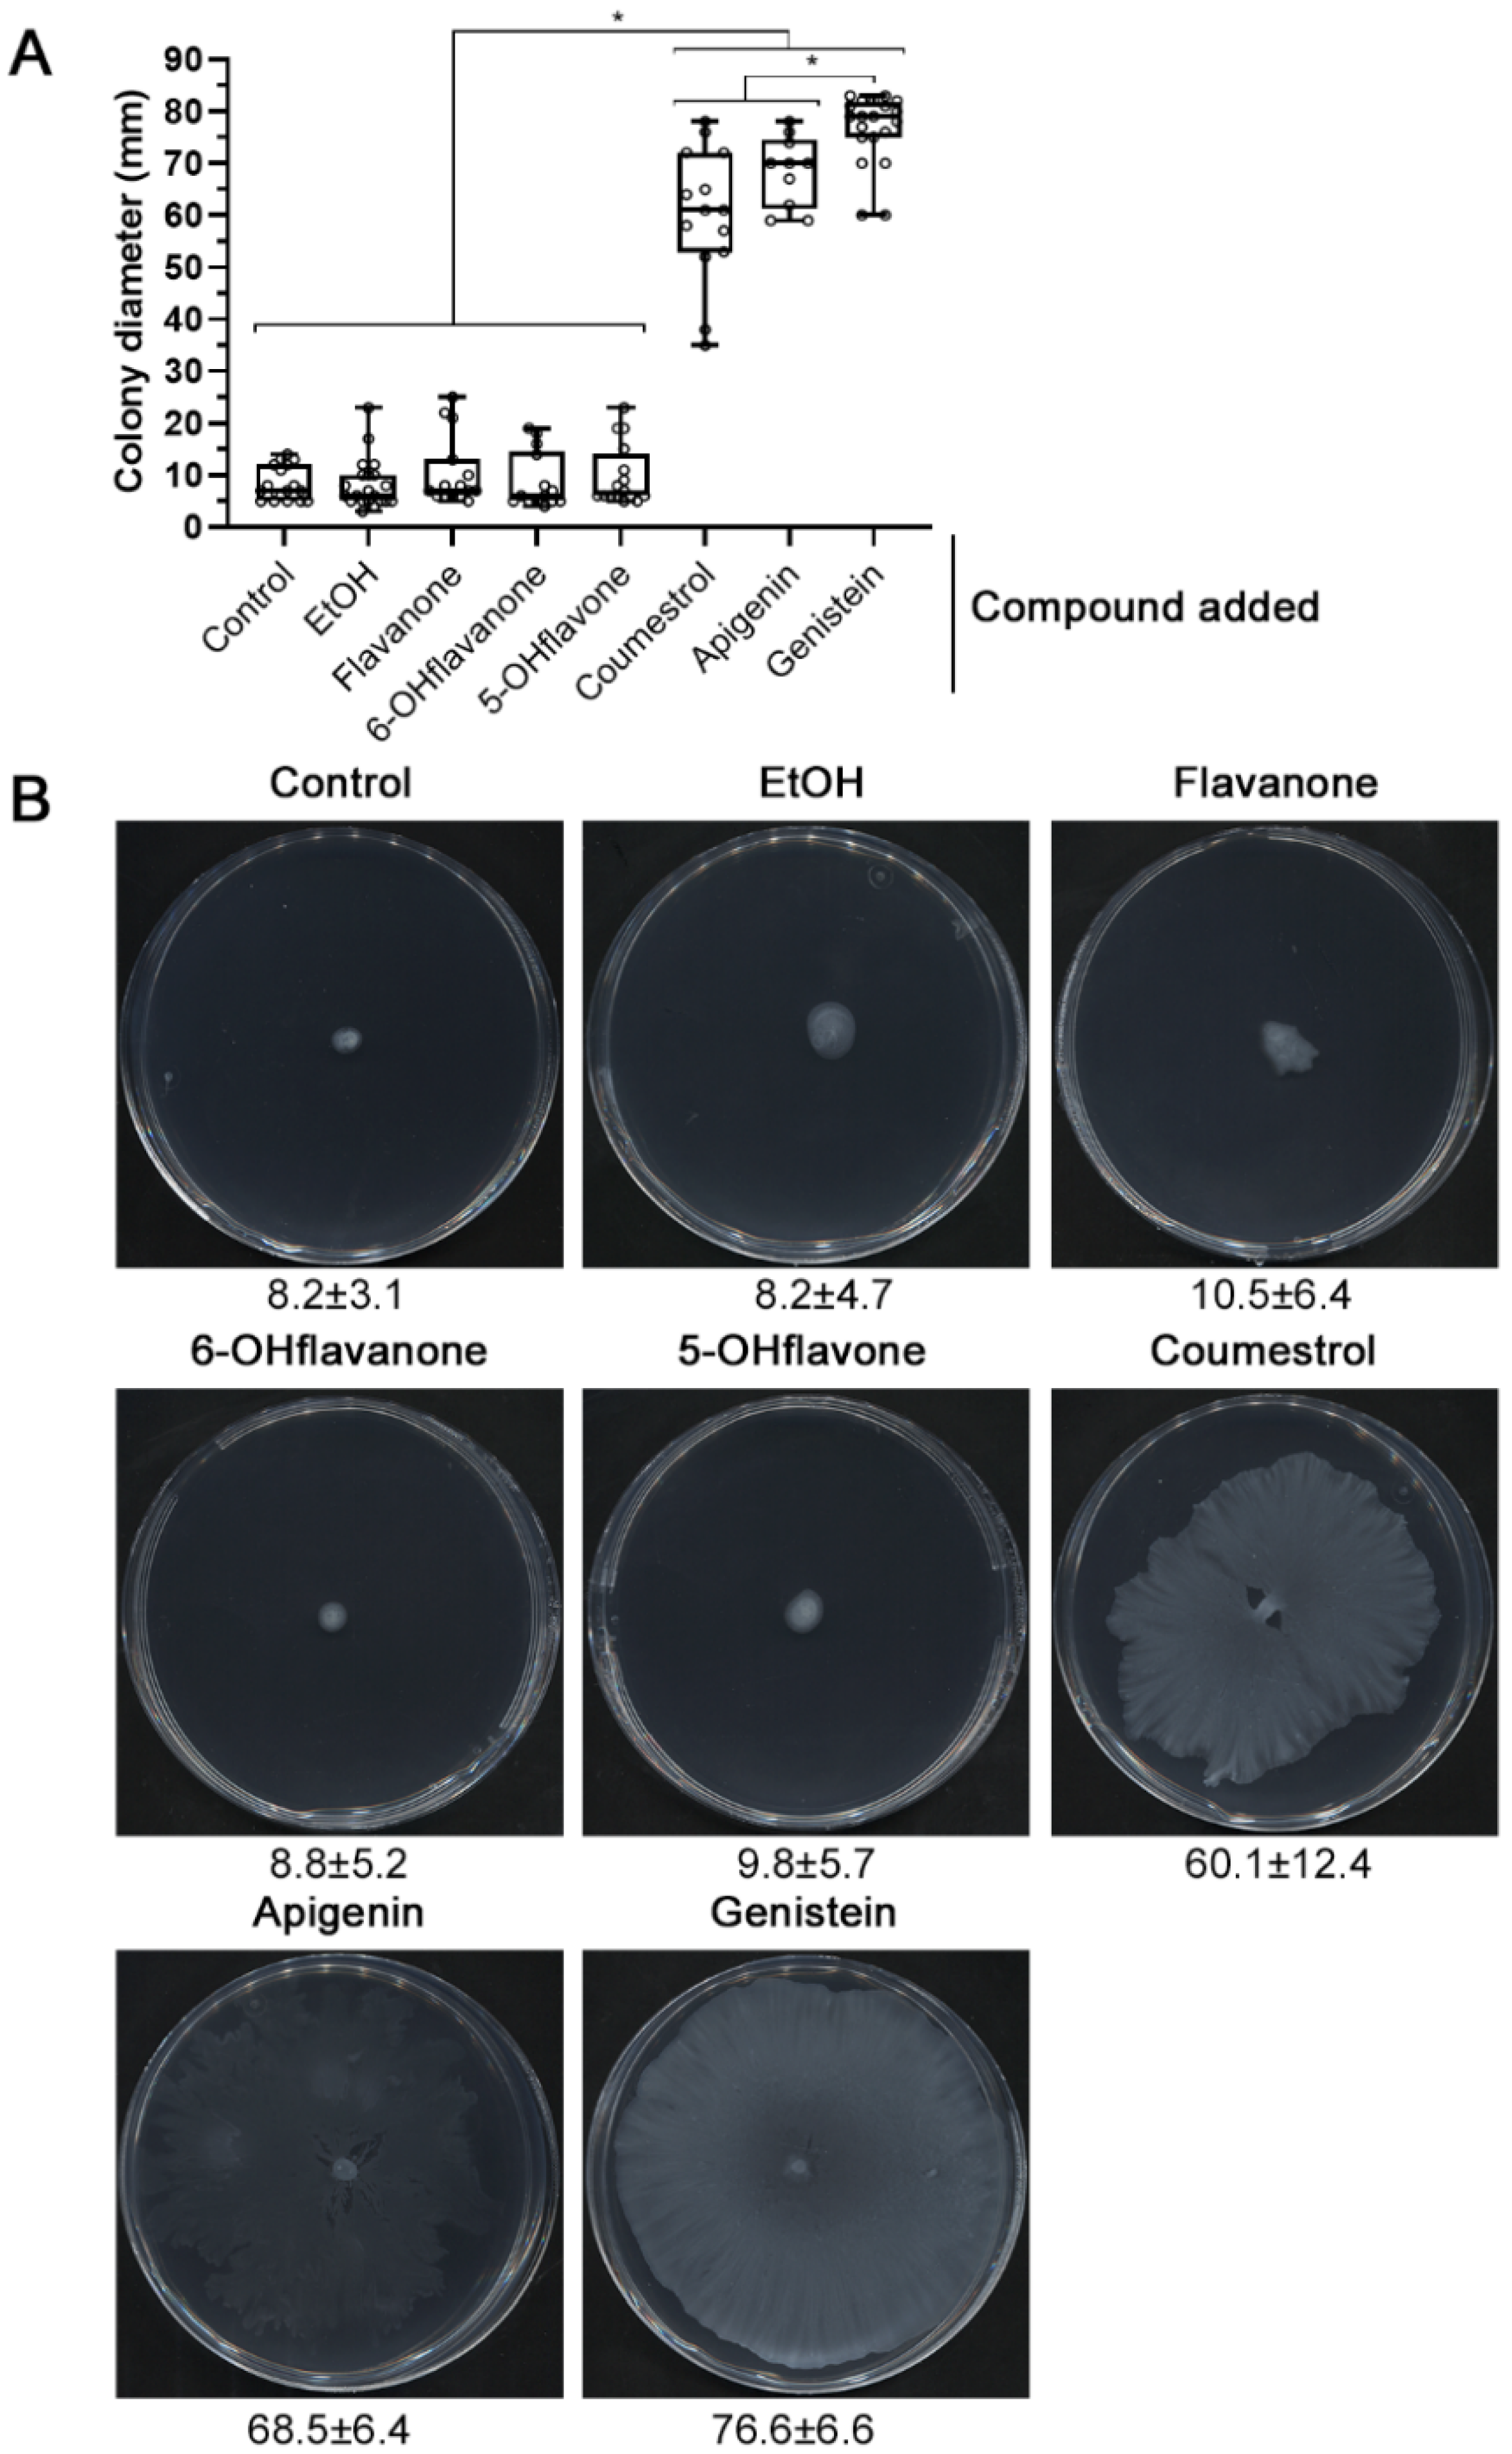
Ijms 23 07698 g001

Surface Motility Regulation of Sinorhizobium fredii HH103 by Plant Flavonoids and the NodD1, TtsI, NolR, and MucR1 Symbiotic Bacterial Regulators
Abstract
:1. Introduction
2. Results
2.1. nod Gene-Inducing Flavonoids Promote Surface Motility in S. fredii HH103
2.2. The HH103 Genistein-Induced Surface Motility Is Mediated by Flagella-Dependent and -Independent Mechanisms
2.3. The HH103 Genistein-Induced Surface Motility Depends on the Regulators NodD1, TtsI and NolR
2.4. S. fredii HH103 Swimming Motility Is Not Affected by Genistein
2.5. A Functional T3SS Is Required for the S. fredii HH103 Genistein-Induced Surface Motility
2.6. Analysing the Putative Role of HH103 Effector Proteins in Genistein-Induced Surface Motility
3. Discussion
4. Materials and Methods
4.1. Basic Molecular and Microbiological Techniques
4.2. Motility Assays
4.3. Statistical Analyses of Motility Data
4.4. Transmission Electron Microscopy (TEM)
Supplementary Materials
Author Contributions
Funding
Institutional Review Board Statement
Informed Consent Statement
Data Availability Statement
Acknowledgments
Conflicts of Interest
References
- Spaink, H.P. Root nodulation and infection factors produced by rhizobial bacteria. Annu. Rev. Microbiol. 2000, 54, 257–288. [Google Scholar] [CrossRef] [PubMed] [Green Version]
- Poole, P.; Ramachandran, V.; Terpolilli, J. Rhizobia: From saprophytes to endosymbionts. Nat. Rev. Microbiol. 2018, 16, 291–303. [Google Scholar] [CrossRef] [PubMed]
- Oldroyd, G.E. Speak, friend, and enter: Signalling systems that promote beneficial symbiotic associations in plants. Nat. Rev. Microbiol. 2013, 11, 252–263. [Google Scholar] [CrossRef] [PubMed]
- Janczarek, M.; Rachwał, K.; Marzec, A.; Grzadziel, J.; Palusińska-Szysz, M. Signal molecules and cell-surface components involved in early stages of the legume-rhizobium interactions. Appl. Soil Ecol. 2015, 85, 94–113. [Google Scholar] [CrossRef]
- López-Baena, F.J.; Ruiz-Sainz, J.E.; Rodríguez-Carvajal, M.A.; Vinardell, J.M. Bacterial molecular signals in the Sinorhizobium fredii-soybean symbiosis. Int. J. Mol. Sci. 2016, 17, 755. [Google Scholar] [CrossRef] [Green Version]
- Roy, S.; Liu, W.; Nandety, R.S.; Crook, A.; Mysore, K.S.; Pislariu, C.I.; Frugoli, J.; Dickstein, R.; Udvardi, M.K. Celebrating 20 years of genetic discoveries in legume nodulation and symbiotic nitrogen fixation. Plant Cell 2020, 32, 15–41. [Google Scholar] [CrossRef] [Green Version]
- Liu, C.-W.; Murray, J.D. The role of flavonoids in nodulation host-range specificity: An update. Plants 2016, 5, 33. [Google Scholar] [CrossRef] [Green Version]
- Perret, X.; Staehelin, C.; Broughton, W.J. Molecular basis of symbiotic promiscuity. Microbiol. Mol. Biol. Rev. 2000, 64, 180–201. [Google Scholar] [CrossRef] [Green Version]
- Peck, M.C.; Fisher, R.F.; Bliss, R.; Long, S.R. Isolation and characterization of mutant Sinorhizobium meliloti NodD1 proteins with altered responses to luteolin. J. Bacteriol. 2013, 195, 3714–3723. [Google Scholar] [CrossRef] [Green Version]
- Suzaki, T.; Yoro, E.; Kawaguchi, M. Leguminous plants: Inventors of root nodules to accommodate symbiotic bacteria. Int. Rev. Cell Mol. Biol. 2015, 316, 111–158. [Google Scholar] [CrossRef]
- Kondorosi, E.; Mergaert, P.; Kereszt, A. A paradigm for endosymbiotic life: Cell differentiation of Rhizobium bacteria provoked by host plant factors. Annu. Rev. Microbiol. 2013, 67, 611–628. [Google Scholar] [CrossRef]
- Madsen, L.N.; Tirichine, L.; Jurkiewicz, A.; Sullivan, J.T.; Heckmann, A.B.; Bek, A.S.; Ronson, C.W.; James, E.K.; Stougaard, J. The molecular network governing nodule organogenesis and infection in the model legume Lotus japonicus. Nat. Commun. 2010, 1, 10. [Google Scholar] [CrossRef] [PubMed] [Green Version]
- Downie, J.A. The roles of extracellular proteins, polysaccharides and signals in the interactions of rhizobia with legume roots. FEMS Microbiol. Rev. 2010, 34, 150–170. [Google Scholar] [CrossRef] [PubMed]
- Staehelin, C.; Krishnan, H.B. Nodulation outer proteins: Double-edged swords of symbiotic rhizobia. Biochem. J. 2015, 470, 263–274. [Google Scholar] [CrossRef] [PubMed] [Green Version]
- Nelson, M.S.; Sadowsky, M.J. Secretion systems and signal exchange between nitrogen-fixing rhizobia and legumes. Front. Plant Sci. 2015, 6, 491. [Google Scholar] [CrossRef] [PubMed] [Green Version]
- Vinardell, J.M.; Ollero, F.J.; Hidalgo, A.; López-Baena, F.J.; Medina, C.; Ivanov-Vangelov, K.; Parada, M.; Madinabeitia, N.; Espuny, M.R.; Bellogín, R.A.; et al. NolR regulates diverse symbiotic signals of Sinorhizobium fredii HH103. Mol. Plant Microbe Interact. 2004, 17, 676–685. [Google Scholar] [CrossRef] [Green Version]
- López-Baena, F.J.; Vinardell, J.M.; Pérez-Montaño, F.; Crespo-Rivas, J.C.; Bellogín, R.A.; Espuny, M.R.; Ollero, F.J. Regulation and symbiotic significance of nodulation outer proteins secretion in Sinorhizobium fredii HH103. Microbiology 2008, 154, 1825–1836. [Google Scholar] [CrossRef] [Green Version]
- Pérez-Montaño, F.; Jiménez-Guerrero, I.; Acosta-Jurado, S.; Navarro-Gómez, P.; Ollero, F.J.; Ruiz-Sainz, J.E.; López-Baena, F.J.; Vinardell, J.M. A transcriptomic analysis of the effect of genistein on Sinorhizobium fredii HH103 reveals novel rhizobial genes putatively involved in symbiosis. Sci. Rep. 2016, 6, 31592. [Google Scholar] [CrossRef] [Green Version]
- Acosta-Jurado, S.; Alias-Villegas, C.; Navarro-Gómez, P.; Zehner, S.; Murdoch, P.S.; Rodríguez-Carvajal, M.A.; Soto, M.J.; Ollero, F.J.; Ruiz-Sainz, J.E.; Göttfert, M.; et al. The Sinorhizobium fredii HH103 MucR1 global regulator is connected with the nod regulon and is required for efficient symbiosis with Lotus burttii and Glycine max cv. Williams. Mol. Plant Microbe Interact. 2016, 29, 700–712. [Google Scholar] [CrossRef] [Green Version]
- Acosta-Jurado, S.; Rodríguez-Navarro, D.N.; Kawaharada, Y.; Rodríguez-Carvajal, M.A.; Gil-Serrano, A.; Soria-Díaz, M.E.; Pérez-Montaño, F.; Fernández-Perea, J.; Niu, Y.; Alias-Villegas, C.; et al. Sinorhizobium fredii HH103 nolR and nodD2 mutants gain capacity for infection thread invasion of Lotus japonicus Gifu and Lotus burttii. Environ. Microbiol. 2019, 21, 1718–1739. [Google Scholar] [CrossRef]
- Acosta-Jurado, S.; Alias-Villegas, C.; Navarro-Gómez, P.; Almozara, A.; Rodríguez-Carvajal, M.A.; Medina, C.; Vinardell, J.M. Sinorhizobium fredii HH103 syrM inactivation affects the expression of a large number of genes, impairs nodulation with soybean and extends the host-range to Lotus japonicus. Environ. Microbiol. 2020, 22, 1104–1124. [Google Scholar] [CrossRef] [PubMed]
- Ma, L.Z.; Wang, D.; Liu, Y.; Zhang, Z.; Wozniak, D.J. Regulation of biofilm exopolysaccharide biosynthesis and degradation in Pseudomonas aeruginosa. Annu. Rev. Microbiol. 2022, 76, 413–433. [Google Scholar] [CrossRef] [PubMed]
- Janczarek, M.; Skorupska, A. Modulation of rosR expression and exopolysaccharide production in Rhizobium leguminosarum bv. trifolii by phosphate and clover root exudates. Int. J. Mol. Sci. 2011, 12, 4132–4155. [Google Scholar] [CrossRef] [PubMed] [Green Version]
- Acosta-Jurado, S.; Navarro-Gómez, P.; Murdoch, P.S.; Crespo-Rivas, J.C.; Jie, S.; Cuesta-Berrio, L.; Ruiz-Sainz, J.E.; Rodríguez-Carvajal, M.Á; Vinardell, J.M. Exopolysaccharide production by Sinorhizobium fredii HH103 is repressed by genistein in a NodD1-dependent manner. PLoS ONE 2016, 11, e0160499. [Google Scholar] [CrossRef] [Green Version]
- Amaya-Gómez, C.V.; Hirsch, A.M.; Soto, M.J. Biofilm formation assessment in Sinorhizobium meliloti reveals interlinked control with surface motility. BMC Microbiol. 2015, 15, 58. [Google Scholar] [CrossRef] [Green Version]
- Fournier, J.; Timmers, A.C.J.; Sieberer, B.J.; Jauneau, A.; Chabaud, M.; Barker, D.G. Mechanism of infection thread elongation in root hairs of Medicago truncatula and dynamic interplay with associated rhizobial colonization. Plant Physiol. 2008, 148, 1985–1995. [Google Scholar] [CrossRef] [Green Version]
- Wheatley, R.M.; Ford, B.L.; Li, L.; Aroney, S.T.N.; Knights, H.E.; Ledermann, R.; East, A.K.; Ramachandran, V.K.; Poole, P.S. Lifestyle adaptations of Rhizobium from rhizosphere to symbiosis. Proc. Natl. Acad. Sci. USA 2020, 117, 23823–23834. [Google Scholar] [CrossRef]
- Aroney, S.T.N.; Poole, P.S.; Sánchez-Cañizares, C. Rhizobial chemotaxis and motility systems at work in the soil. Front. Plant Sci. 2021, 12, 725338. [Google Scholar] [CrossRef]
- Zheng, H.; Mao, Y.; Teng, J.; Zhu, Q.; Ling, J.; Zhong, Z. Flagellar-dependent motility in Mesorhizobium tianshanense is involved in the early stage of plant host interaction: Study of an flgE mutant. Curr. Microbiol. 2015, 70, 219–227. [Google Scholar] [CrossRef]
- Mellor, H.Y.; Glenn, A.R.; Arwas, R.; Dilworth, M.J. Symbiotic and competitive properties of motility mutants of Rhizobium trifolii TA1. Arch. Microbiol. 1987, 148, 34–39. [Google Scholar] [CrossRef]
- Caetano-Anollés, G.; Wall, L.G.; De Micheli, A.T.; Macchi, E.M.; Bauer, W.D.; Favelukes, G. Role of motility and chemotaxis in efficiency of nodulation by Rhizobium meliloti. Plant Physiol. 1988, 86, 1228–1235. [Google Scholar] [CrossRef] [PubMed] [Green Version]
- Malek, W. The role of motility in the efficiency of nodulation by Rhizobium meliloti. Arch. Microbiol. 1992, 158, 26–28. [Google Scholar] [CrossRef]
- Bernabéu-Roda, L.; Calatrava-Morales, N.; Cuéllar, V.; Soto, M.J. Characterization of surface motility in Sinorhizobium meliloti: Regulation and role in symbiosis. Symbiosis 2015, 67, 79–90. [Google Scholar] [CrossRef]
- Uchiumi, T.; Ohwada, T.; Itakura, M.; Mitsui, H.; Nukui, N.; Dawadi, P.; Kaneko, T.; Tabata, S.; Yokoyama, T.; Tejima, K.; et al. Expression islands clustered on the symbiosis island of the Mesorhizobium loti genome. J. Bacteriol. 2004, 186, 2439–2448. [Google Scholar] [CrossRef] [Green Version]
- Tambalo, D.D.; Bustard, D.E.; Del Bel, K.L.; Koval, S.F.; Khan, M.F.; Hynes, M.F. Characterization and functional analysis of seven flagellin genes in Rhizobium leguminosarum bv. viciae. Characterization of R. leguminosarum flagellins. BMC Microbiol. 2010, 10, 219. [Google Scholar] [CrossRef] [Green Version]
- Tatsukami, Y.; Nambu, M.; Morisaka, H.; Kuroda, K.; Ueda, M. Disclosure of the differences of Mesorhizobium loti under the free-living and symbiotic conditions by comparative proteome analysis without bacteroid isolation. BMC Microbiol. 2013, 13, 180. [Google Scholar] [CrossRef] [Green Version]
- Henrichsen, J. Bacterial surface translocation: A survey and a classification. Bacteriol. Rev. 1972, 36, 478–503. [Google Scholar] [CrossRef] [PubMed]
- Kearns, D.B. A field guide to bacterial swarming motility. Nat. Rev. Microbiol. 2010, 8, 634–644. [Google Scholar] [CrossRef] [PubMed] [Green Version]
- Hölscher, T.; Kovács, A.T. Sliding on the surface: Bacterial spreading without an active motor. Environ. Microbiol. 2017, 19, 2537–2545. [Google Scholar] [CrossRef]
- Mattingly, A.E.; Weaver, A.A.; Dimkovikj, A.; Shrout, J.D. Assessing travel conditions: Environmental and host influences on bacterial surface motility. J. Bacteriol. 2018, 200, e00014-18. [Google Scholar] [CrossRef] [Green Version]
- Wadhwa, N.; Berg, H.C. Bacterial motility: Machinery and mechanisms. Nat. Rev. Microbiol. 2022, 20, 161–173. [Google Scholar] [CrossRef] [PubMed]
- Soto, M.J.; Fernández-Pascual, M.; Sanjuán, J.; Olivares, J. A fadD mutant of Sinorhizobium meliloti shows multicellular swarming migration and is impaired in nodulation efficiency on alfalfa roots. Mol. Microbiol. 2002, 43, 371–382. [Google Scholar] [CrossRef] [PubMed] [Green Version]
- Daniels, R.; Reynaert, S.; Hoekstra, H.; Verreth, C.; Janssens, J.; Braeken, K.; Fauvart, M.; Beullens, S.; Heusdens, C.; Lambrichts, I.; et al. Quorum signal molecules as biosurfactants affecting swarming in Rhizobium etli. Proc. Natl. Acad. Sci. USA 2006, 103, 14965–14970. [Google Scholar] [CrossRef] [PubMed] [Green Version]
- Tambalo, D.D.; Yost, C.K.; Hynes, M.F. Characterization of swarming motility in Rhizobium leguminosarum bv. viciae. FEMS Microbiol. Lett. 2010, 307, 165–174. [Google Scholar] [CrossRef] [PubMed]
- Nogales, J.; Bernabéu-Roda, L.; Cuéllar, V.; Soto, M.J. ExpR is not required for swarming but promotes sliding in Sinorhizobium meliloti. J. Bacteriol. 2012, 194, 2027–2035. [Google Scholar] [CrossRef] [Green Version]
- Covelli, J.M.; Althabegoiti, M.J.; López, M.F.; Lodeiro, A.R. Swarming motility in Bradyrhizobium japonicum. Res. Microbiol. 2013, 164, 136–144. [Google Scholar] [CrossRef]
- Bernabéu-Roda, L.M.; López-Ráez, J.A.; Soto, M.J. Analyzing the effect of strigolactones on the motility behavior of Rhizobia. In Strigolactones. Methods in Molecular Biology; Prandi, C., Cardinale, F., Eds.; Humana: New York, NY, USA, 2021; Volume 2309, pp. 91–103. [Google Scholar] [CrossRef]
- Dilanji, G.E.; Teplitski, M.; Hagen, S.J. Entropy-driven motility of Sinorhizobium meliloti on a semi-solid surface. Proc. Biol. Sci. 2014, 281, 20132575. [Google Scholar] [CrossRef] [Green Version]
- Nogales, J.; Domínguez-Ferreras, A.; Amaya-Gómez, C.V.; van Dillewijn, P.; Cuéllar, V.; Sanjuán, J.; Olivares, J.; Soto, M.J. Transcriptome profiling of a Sinorhizobium meliloti fadD mutant reveals the role of rhizobactin 1021 biosynthesis and regulation genes in the control of swarming. BMC Genom. 2010, 11, 157. [Google Scholar] [CrossRef] [Green Version]
- Tambalo, D.D.; Vanderlinde, E.M.; Robinson, S.; Hamillawewa, A.; Hynes, M.F.; Yost, C.K. Legume seed exudates and Physcomitrella patens extracts influence swarming behaviour in Rhizobium leguminosarum. Can. J. Microbiol. 2014, 60, 15–24. [Google Scholar] [CrossRef]
- Peláez-Vico, M.A.; Bernabéu, L.; Kohlen, W.; Soto, M.J.; López-Ráez, J.A. Strigolactones in the Rhizobium-legume symbiosis: Stimulatory effect on bacterial surface motility and down-regulation of their levels in nodulated plants. Plant Sci. 2016, 246, 119–127. [Google Scholar] [CrossRef]
- Rodríguez-Navarro, D.N.; Rodríguez-Carvajal, M.A.; Acosta-Jurado, S.; Soto, M.J.; Margaret, I.; Crespo-Rivas, J.C.; Sanjuan, J.; Temprano, F.; Gil-Serrano, A.; Ruiz-Sainz, J.E.; et al. Structure and biological roles of Sinorhizobium fredii HH103 exopolysaccharide. PLoS ONE 2014, 9, e115391. [Google Scholar] [CrossRef] [PubMed] [Green Version]
- Vinardell, J.M.; López-Baena, F.J.; Hidalgo, A.; Ollero, F.J.; Bellogín, R.; Espuny, M.R.; Temprano, F.; Romero, F.; Krishnan, H.B.; Pueppke, S.G.; et al. The effect of FITA mutations on the symbiotic properties of Sinorhizobium fredii varies in a chromosomal-background-dependent manner. Arch. Microbiol. 2004, 181, 144–154. [Google Scholar] [CrossRef] [PubMed]
- Buendía-Clavería, A.M.; Moussaid, A.; Ollero, F.J.; Vinardell, J.M.; Torres, A.; Moreno, J.; Gil-Serrano, A.M.; Rodríguez-Carvajal, M.A.; Tejero-Mateo, P.; Peart, J.L.; et al. A purL mutant of Sinorhizobium fredii HH103 is symbiotically defective and altered in its lipopolysaccharide. Microbiology 2003, 149, 1807–1818. [Google Scholar] [CrossRef] [PubMed]
- Navarro-Gómez, P. Identificación y Estudio de Genes Simbióticos de Sinorhizobium fredii HH103 Previamente no Caracterizados. Ph.D. Thesis, University of Seville, Seville, Spain, 25 September 2020. [Google Scholar]
- de Lyra, M.C.C.P.; Lopez-Baena, F.J.; Madinabeitia, N.; Vinardell, J.M.; Espuny, M.R.; Cubo, M.T.; Bellogin, R.A.; Ruiz-Sainz, J.E.; Ollero, F.J. Inactivation of the Sinorhizobium fredii HH103 rhcJ gene abolishes nodulation outer proteins (Nops) secretion and decreases the symbiotic capacity with soybean. Int. Microbiol. 2006, 9, 125–133. [Google Scholar] [CrossRef]
- López-Baena, F.J. Las Proteínas Nop de Sinorhizobium fredii HH103: Regulación e Implicación en la Simbiosis con la soja (Glycine max [L.] Merrill). Ph.D. Thesis, University of Seville, Seville, Spain, 18 April 2008. [Google Scholar]
- Jiménez-Guerrero, I.; Pérez-Montaño, F.; Medina, C.; Ollero, F.J.; López-Baena, F.J. The Sinorhizobium (Ensifer) fredii HH103 nodulation outer protein NopI is a determinant for efficient nodulation of soybean and cowpea plants. Appl. Environ. Microbiol. 2017, 83, e02770-16. [Google Scholar] [CrossRef] [Green Version]
- López-Baena, F.J.; Monreal, J.A.; Pérez-Montaño, F.; Guasch-Vidal, B.; Bellogín, R.A.; Vinardell, J.M.; Ollero, F.J. The absence of Nops secretion in Sinorhizobium fredii HH103 increases GmPR1 expression in Williams soybean. Mol. Plant Microbe Interact. 2009, 22, 1445–1454. [Google Scholar] [CrossRef] [Green Version]
- Jiménez-Guerrero, I.; Pérez-Montaño, F.; Monreal, J.A.; Preston, G.M.; Fones, H.; Vioque, B.; Ollero, F.J.; López-Baena, F.J. The Sinorhizobium (Ensifer) fredii HH103 Type 3 Secretion System suppresses early defense responses to effectively nodulate soybean. Mol. Plant Microbe Interact. 2015, 28, 790–799. [Google Scholar] [CrossRef] [Green Version]
- Jiménez-Guerrero, I.; Pérez-Montaño, F.; Medina, C.; Ollero, F.J.; López-Baena, F.J. NopC is a Rhizobium-specific Type 3 Secretion System effector secreted by Sinorhizobium (Ensifer) fredii HH103. PLoS ONE 2015, 10, e0142866. [Google Scholar] [CrossRef] [Green Version]
- Jiménez-Guerrero, I.; Pérez-Montaño, F.; Zdyb, A.; Beutler, M.; Werner, G.; Göttfert, M.; Ollero, F.J.; Vinardell, J.M.; López-Baena, F.J. GunA of Sinorhizobium (Ensifer) fredii HH103 is a T3SS-secreted cellulase that differentially affects symbiosis with cowpea and soybean. Plant Soil 2019, 435, 15–26. [Google Scholar] [CrossRef]
- Jiménez-Guerrero, I.; Acosta-Jurado, S.; Medina, C.; Ollero, F.J.; Alias-Villegas, C.; Vinardell, J.M.; Pérez-Montaño, F.; López-Baena, F.J. The Sinorhizobium fredii HH103 type III secretion system effector NopC blocks nodulation with Lotus japonicus Gifu. J. Exp. Bot. 2020, 71, 6043–6056. [Google Scholar] [CrossRef]
- Górniak, I.; Bartoszewski, R.; Króliczewski, J. Comprehensive review of antimicrobial activities of plant flavonoids. Phytochem. Rev. 2019, 18, 241–272. [Google Scholar] [CrossRef] [Green Version]
- Pruteanu, M.; Hernandez Lobato, J.I.; Stach, T.; Hengge, R. Common plant flavonoids prevent the assembly of amyloid curli fibres and can interfere with bacterial biofilm formation. Environ. Microbiol. 2020, 22, 5280–5299. [Google Scholar] [CrossRef] [PubMed]
- Vargas, P.; Farias, G.A.; Nogales, J.; Prada, H.; Carvajal, V.; Baron, M.; Rivilla, R.; Martin, M.; Olmedilla, A.; Gallegos, M.T. Plant flavonoids target Pseudomonas syringae pv. tomato DC3000 flagella and type III secretion system. Environ. Microbiol. Rep. 2013, 5, 841–850. [Google Scholar] [CrossRef]
- Compton, K.K.; Hildreth, S.B.; Helm, R.F.; Scharf, B.E. An updated perspective on Sinorhizobium meliloti chemotaxis to alfalfa flavonoids. Front. Microbiol. 2020, 11, 581482. [Google Scholar] [CrossRef] [PubMed]
- Vinardell, J.M.; Acosta-Jurado, S.; Zehner, S.; GÖttfert, M.; Becker, A.; Baena, I.; Blom, J.; Crespo-Rivas, J.C.; Goesmann, A.; Jaenicke, S.; et al. The Sinorhizobium fredii HH103 genome: A comparative analysis with S. fredii strains differing in their symbiotic behavior with soybean. Mol. Plant Microbe Interact. 2015, 28, 811–824. [Google Scholar] [CrossRef] [PubMed] [Green Version]
- Overhage, J.; Bains, M.; Brazas, M.D.; Hancock, R.E. Swarming of Pseudomonas aeruginosa is a complex adaptation leading to increased production of virulence factors and antibiotic resistance. J. Bacteriol. 2008, 190, 2671–2679. [Google Scholar] [CrossRef] [Green Version]
- Gode-Potratz, C.J.; Chodur, D.M.; McCarter, L.L. Calcium and iron regulate swarming and type III secretion in Vibrio parahaemolyticus. J. Bacteriol. 2010, 192, 6025–6038. [Google Scholar] [CrossRef] [Green Version]
- Diaz, M.R.; King, J.M.; Yahr, T.L. Intrinsic and Extrinsic Regulation of Type III Secretion Gene Expression in Pseudomonas Aeruginosa. Front. Microbiol. 2011, 2, 89. [Google Scholar] [CrossRef] [Green Version]
- Kinouani-Kinavouidi, D.J.; Kayath, C.A.; Nguimbi, E. Invasion of epithelial cells is correlated with secretion of biosurfactant via the Type 3 Secretion System (T3SS) of Shigella flexneri. J. Pathog. 2020, 2020, 3062821. [Google Scholar] [CrossRef]
- Janczarek, M.; Jaroszuk-Ściseł, J.; Skorupska, A. Multiple copies of rosR and pssA genes enhance exopolysaccharide production, symbiotic competitiveness and clover nodulation in Rhizobium leguminosarum bv. trifolii. Antonie Leeuwenhoek 2009, 96, 471–486. [Google Scholar] [CrossRef]
- Janczarek, M.; Kutkowska, J.; Piersiak, T.; Skorupska, A. Rhizobium leguminosarum bv. trifolii rosR is required for interaction with clover, biofilm formation and adaptation to the environment. BMC Microbiol. 2010, 10, 284. [Google Scholar] [CrossRef] [PubMed] [Green Version]
- Rachwał, K.; Matczyńska, E.; Janczarek, M. Transcriptome profiling of a Rhizobium leguminosarum bv. trifolii rosR mutant reveals the role of the transcriptional regulator RosR in motility, synthesis of cell-surface components, and other cellular processes. BMC Genom. 2015, 16, 1111. [Google Scholar] [CrossRef] [PubMed] [Green Version]
- Jiao, J.; Wu, L.J.; Zhang, B.; Hu, Y.; Li, Y.; Zhang, X.X.; Guo, H.J.; Liu, L.X.; Chen, W.X.; Zhang, Z.; et al. MucR is required for transcriptional activation of conserved ion transporters to support nitrogen fixation of Sinorhizobium fredii in soybean nodules. Mol. Plant Microbe Interact. 2016, 29, 352–361. [Google Scholar] [CrossRef] [PubMed] [Green Version]
- Fujishige, N.A.; Lum, M.R.; De Hoff, P.L.; Whitelegge, J.P.; Faull, K.F.; Hirsch, A.M. Rhizobium common nod genes are required for biofilm formation. Mol. Microbiol. 2008, 67, 504–515. [Google Scholar] [CrossRef] [Green Version]
- Madinabeitia, N.; Bellogín, R.A.; Buendía-Clavería, A.M.; Camacho, M.; Cubo, T.; Espuny, M.R.; Gil-Serrano, A.M.; Lyra, M.C.; Moussaid, A.; Ollero, F.J.; et al. Sinorhizobium fredii HH103 has a truncated nolO gene due to a -1 frameshift mutation that is conserved among other geographically distant S. fredii strains. Mol. Plant Microbe Interact. 2002, 15, 150–159. [Google Scholar] [CrossRef] [Green Version]
- Beringer, J.E. R factor transfer in Rhizobium leguminosarum. J. Gen. Microbiol. 1974, 84, 188–198. [Google Scholar] [CrossRef] [Green Version]
- Sourjik, V.; Schmitt, R. Different roles of CheY1 and CheY2 in the chemotaxis of Rhizobium meliloti. Mol. Microbiol. 1996, 22, 427–436. [Google Scholar] [CrossRef]
- Robertsen, B.K.; Aiman, P.; Darwill, A.G.; Mcneil, M.; Albersheim, P. The structure of acidic extracellular polysaccharides secreted by Rhizobium leguminosarum and Rhizobium trifolii. Plant Physiol. 1981, 67, 389–400. [Google Scholar] [CrossRef] [Green Version]

Publisher’s Note: MDPI stays neutral with regard to jurisdictional claims in published maps and institutional affiliations. |
© 2022 by the authors. Licensee MDPI, Basel, Switzerland. This article is an open access article distributed under the terms and conditions of the Creative Commons Attribution (CC BY) license (https://creativecommons.org/licenses/by/4.0/).
Share and Cite
Alías-Villegas, C.; Fuentes-Romero, F.; Cuéllar, V.; Navarro-Gómez, P.; Soto, M.J.; Vinardell, J.-M.; Acosta-Jurado, S. Surface Motility Regulation of Sinorhizobium fredii HH103 by Plant Flavonoids and the NodD1, TtsI, NolR, and MucR1 Symbiotic Bacterial Regulators. Int. J. Mol. Sci. 2022, 23, 7698. https://doi.org/10.3390/ijms23147698
Alías-Villegas C, Fuentes-Romero F, Cuéllar V, Navarro-Gómez P, Soto MJ, Vinardell J-M, Acosta-Jurado S. Surface Motility Regulation of Sinorhizobium fredii HH103 by Plant Flavonoids and the NodD1, TtsI, NolR, and MucR1 Symbiotic Bacterial Regulators. International Journal of Molecular Sciences. 2022; 23(14):7698. https://doi.org/10.3390/ijms23147698
Chicago/Turabian StyleAlías-Villegas, Cynthia, Francisco Fuentes-Romero, Virginia Cuéllar, Pilar Navarro-Gómez, María J. Soto, José-María Vinardell, and Sebastián Acosta-Jurado. 2022. "Surface Motility Regulation of Sinorhizobium fredii HH103 by Plant Flavonoids and the NodD1, TtsI, NolR, and MucR1 Symbiotic Bacterial Regulators" International Journal of Molecular Sciences 23, no. 14: 7698. https://doi.org/10.3390/ijms23147698
APA StyleAlías-Villegas, C., Fuentes-Romero, F., Cuéllar, V., Navarro-Gómez, P., Soto, M. J., Vinardell, J.-M., & Acosta-Jurado, S. (2022). Surface Motility Regulation of Sinorhizobium fredii HH103 by Plant Flavonoids and the NodD1, TtsI, NolR, and MucR1 Symbiotic Bacterial Regulators. International Journal of Molecular Sciences, 23(14), 7698. https://doi.org/10.3390/ijms23147698

